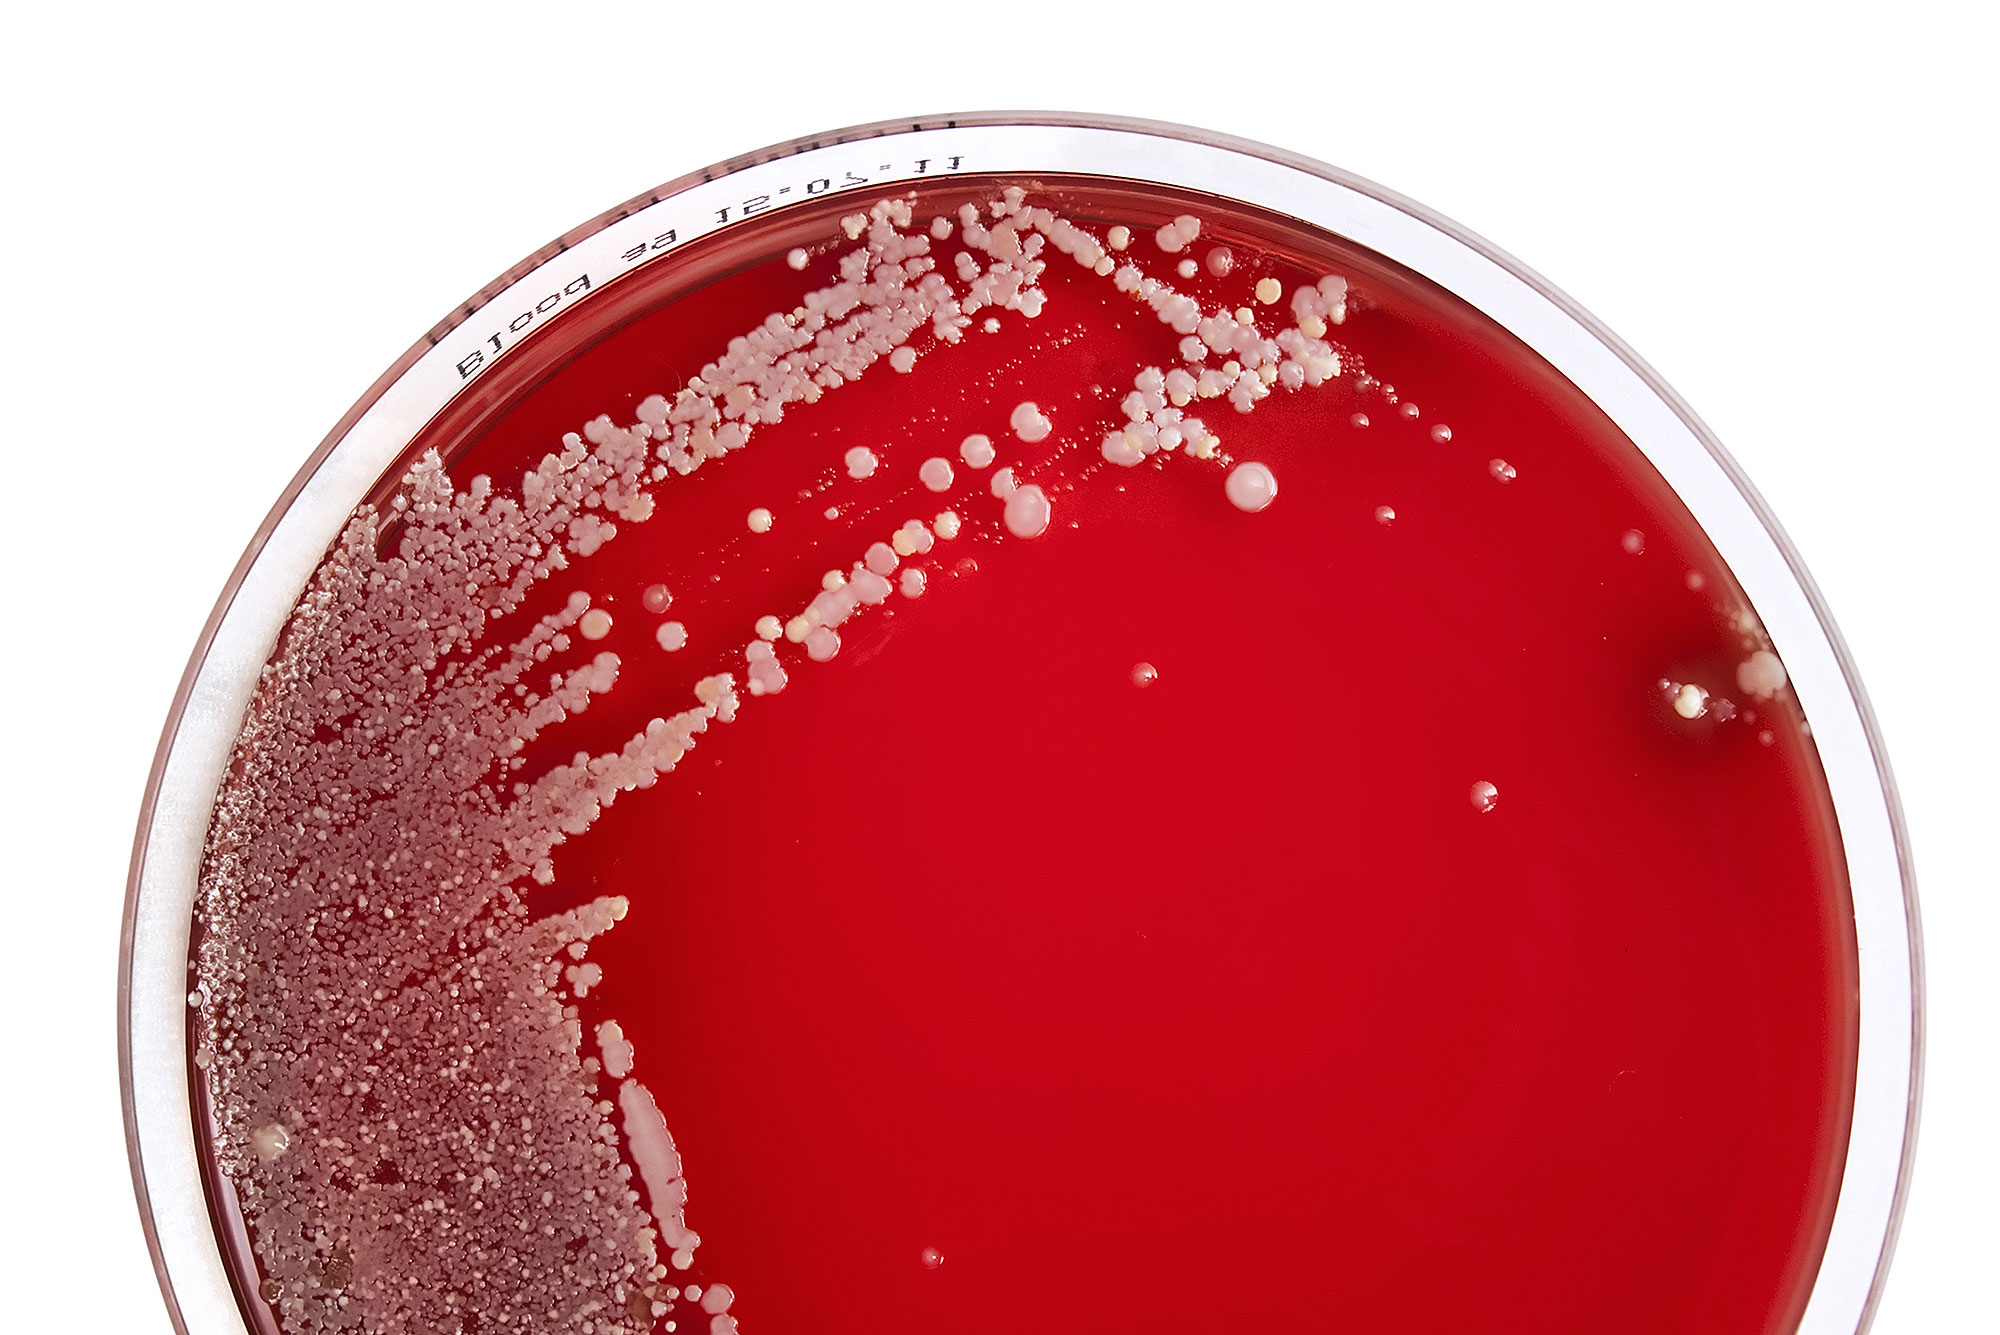

Willkommen im
MVZ SYNLAB Wuppertal
Praxissprechzeiten
| Montag – Freitag |
8.00 Uhr — 12.00 Uhr |
Laborzeiten
| Montag – Donnerstag |
8.00 Uhr — 15.00 Uhr |
| Freitag |
8.00 Uhr — 13.30 Uhr |